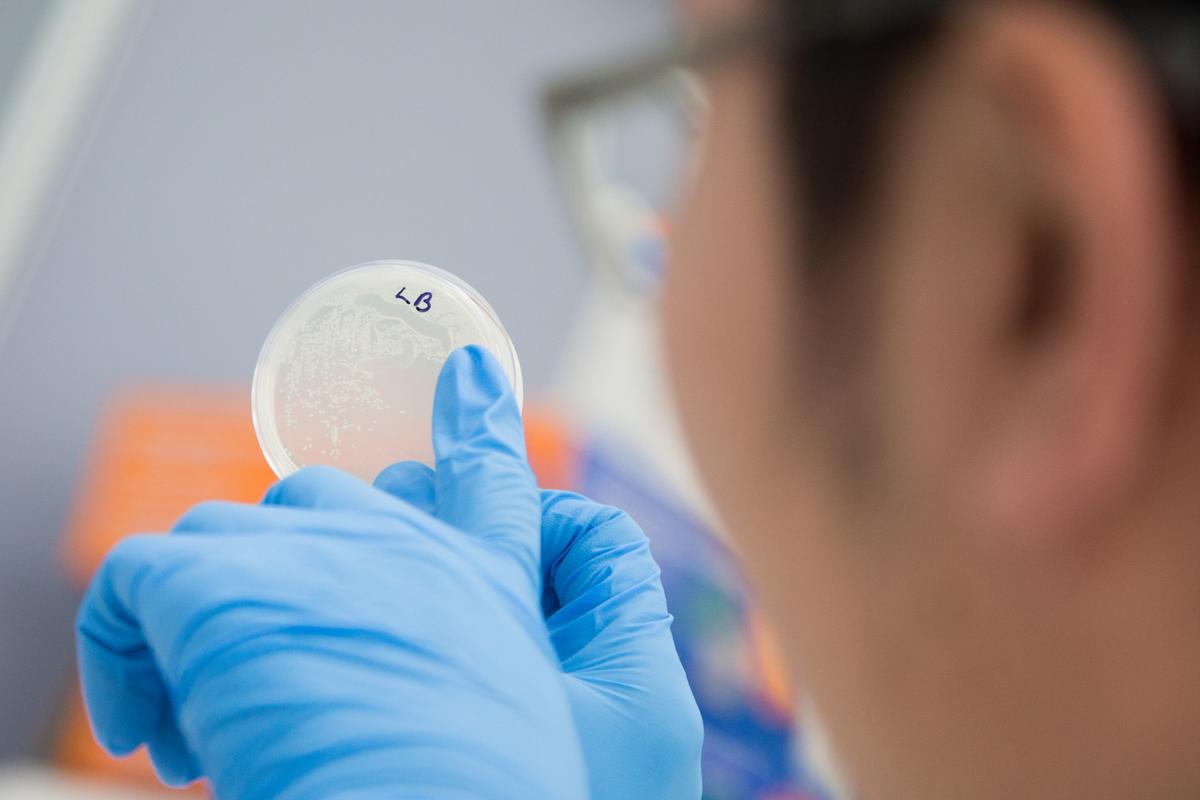
Gallery Image

SCIENCE

NATIONAL SCIENCE WEEK AT MCKINNON
National Science Week (11-19 August) is an annual celebration of science and technology. Our school has a proud tradition of celebrating this week by offering a number of activities, both in and out of class, to engage and ignite the scientific curiosity of our students.
In class, students were asked to investigate questions such as, “What makes popcorn pop?”, “Why don’t oceans freeze?”, and “Why does the taller candle of the two get extinguished first?”. Among the experiments on offer, creating a ‘density tower’ proved popular. In this activity, students had to determine which liquids were more dense than others to successfully create a 4-layer density tower. Also popular, was the Planks workshop with the Year 9s. After a presentation on applicable engineering principles the students had to create structures using hundreds of small planks. Our Year 7s attended a zoo incursion, where they got the chance to get up-close and personal with a number of Australian native animals. Year 8 Science Survivor saw the islands compete against each other in science general knowledge quizzes, a car design challenge and a paper tower challenge.
During lunchtimes, activities on offer included: viewing films from the National Science Film Festival, building robotics, entering virtual reality by using an Oculus Rift and building a floating home.
Our Year 10 Biology students were given the opportunity to work with, and chat to, some former students who now do incredible work in the field of Science. This included Professor Jim Bishop (Cancer expert from the University of Melbourne and former Australian Chief Medical Officer), Professor Gab Kovacs AM (pioneer in the development and success of IVF) and Dr Lev Kats (group leader in the Cancer Therapeutics Program at Peter MacCallum). Meanwhile our Year 12 Biology students attended a workshop run by Ass Professor Kaylene Simpson who runs a cancer genomics laboratory at Peter MacCallum Cancer Center. She worked with the students on rational drug design and cancer.
On behalf of the Science Faculty and our students, we would like to thank our Science Key Learning Area Manager, Therese Sweeney for organising and coordinating all these amazing events.
Cherie Marks
Science Teacher
YEAR 12 BIOLOGY INCURSION
On Wednesday 5 September all Year 12 McKinnon biology students attended an incursion where they got hands on experience with genetic engineering technologies. The students performed a bacterial transformation where they inserted a fluorescent gene from a jelly fish into bacterial. Our students were mentored in small groups by PhD and masters students from Peter MacCallum Cancer Centre who were able to guide and give some insight to our budding biologists as to some of the groundbreaking research that is currently taking place.
This was a wonderful learning experience and we look forward to building upon this year's success. Our students were guided through the task whilst discussing the amazing research the postgraduate students are currently doing with cancer treatment. Thank you to Mr Keefe Chan, Mr Zheng Fan, Mr Athanasios Koulis and ex McKinnon student Mr Anthony Xuan for volunteering their time to come and help throughout the day.
Emily Nicholls
Biology Teacher & Incursion Organiser